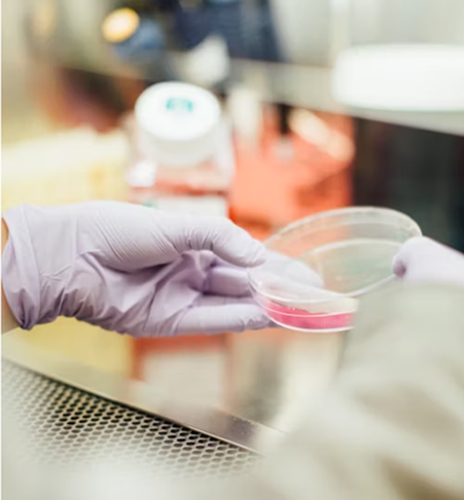
Item Image

Service Title Goes Here

+3.1K
Yearly Tests
Conducted
22
Number of Laboratory
Locations
2.2 K
Serviced Patients
99%
TheAccuracy Rate
Optional Title for service description goes here
We pride ourselves on the trained skills needed for the preparation of diversified testing. We are of the sound belief that timely diagnosis could cast off the scar of many of the grave diseases. It can be made possible if you consult your doctor for suspected diseases.
- All reports for clients are made simple and easy to understand
- User- friendly website offers custom settings for each physician
- We customize panels to meet physician’s needs.

Latest Equipment
Quality Service
Skilled Team
Positive Reviews

Service Hilghlight 1

Service Hilghlight 2
Domains & Specialities 1
In publishing and graphic design, Lorem ipsum is a placeholder text commonly used for demo.

In publishing and graphic design, Lorem ipsum is a placeholder text commonly used for demo.

In publishing and graphic design, Lorem ipsum is a placeholder text commonly used for demo.

In publishing and graphic design, Lorem ipsum is a placeholder text commonly used for demo.
Popular Procedures
- Cosmetic Surgery
- Plastic surgery
- Rhinoplasty
- Liposuction
- Male breast Reduction
- FUE Hair Transplant
- Botox Treatment
- Hair Fall Treatment
- Breast Lift Surgery
- Abdominoplasty Surgery
- Rhinoplasty
- Hymenoplasty
- Laser Hair Removal
- Tummy Tuck

We pride ourselves on the trained skills needed for the preparation of diversified testing. We are of the sound belief that timely diagnosis could cast off the scar of many of the grave diseases.

All medical facility
Lowest fees in city
May find some redeeming value with wait for it, dummy copy.
Experienced Doctor
Embark on your health journey at Cell’s clinics, Laboratory, for all the Lorem ipsum texts.

5000+ Happy Patient
Embark on your health journey at Cell’s clinics, Laboratory, for all the Lorem ipsum texts.
Common Questions About THE SERVICE
1. How can I improve my oral Hygiene?
Everyone’s needs are different, so have a chat to your dentist about how often you need to have your teeth checked by them based on the condition of your mouth, teeth and gums. It’s recommended that children see their dentist at least once a year.
2. How do I know if my teeth are healthy?
Everyone’s needs are different, so have a chat to your dentist about how often you need to have your teeth checked by them based on the condition of your mouth, teeth and gums. It’s recommended that children see their dentist at least once a year.
3.Why are regular dental assessments so important?
Everyone’s needs are different, so have a chat to your dentist about how often you need to have your teeth checked by them based on the condition of your mouth, teeth and gums. It’s recommended that children see their dentist at least once a year.
4. How often one should visit his dentist?
Everyone’s needs are different, so have a chat to your dentist about how often you need to have your teeth checked by them based on the condition of your mouth, teeth and gums. It’s recommended that children see their dentist at least once a year.

Videos About the Service





OTHER SERVICES







